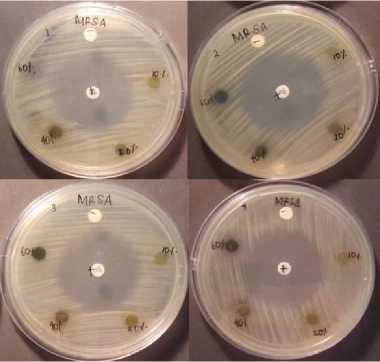

UJI DAYA HAMBAT EKSTRAK ETIL ASETAT DAUN KAMBOJA (Plumeria rubra var. acutifolia) TERHADAP PERTUMBUHAN BAKTERI METHICILLIN RESISTANT Staphylococcus aureus SECARA IN VITRO
on
ISSN: 2597-8012 JURNAL MEDIKA UDAYANA, VOL. 9 NO.4,APRIL, 2020

Diterima:15-03-2020 Revisi:20-03-2020 Accepted: 25-03-2020
UJI DAYA HAMBAT EKSTRAK ETIL ASETAT DAUN KAMBOJA (Plumeria rubra var. acutifolia) TERHADAP PERTUMBUHAN BAKTERI METHICILLIN RESISTANT Staphylococcus aureus SECARA IN VITRO
Ni Luh Made Rasmawati 1, Ni Nengah Dwi Fatmawati2
1)Mahasiswa Program Studi Pendidikan Dokter, Fakultas Kedokteran, Universitas Udayana
2)Bagian/SMF Mikrobiologi Klinik, Program Studi Pendidikan Dokter Fakultas Kedokteran Universitas Udayana, Jl. PB. Sudirman, Denpasar, Bali, Indonesia Corresponding Author : Ni Luh Made Rasmawati rasmawati1210@gmail.com
ABSTRAK
Penggunaan antibiotik yang kurang bijaksana dapat memicu terjadinya resistensi bakteri terhadap antibiotik. Salah satu bakteri yang kini mengalami resistensi terhadap berbagai macam antibiotik adalah Methicillin-Resistant Staphylococcus aureus (MRSA). Kandungan flavonoid dan alkaloid yang dilaporakan pada daun tanaman kamboja (Plumeria rubra var. acutifolia) memiliki aktivitas anti bakteri sehingga penelitian lebih mendalam terkait efikasi senyawa tersebut akan menarik untuk dikaji. Tujuan penelitian ini adalah untuk mengetahui apakah ekstrak etil asetat daun kamboja (Plumeria rubra var. acutifolia) dapat menghambat pertumbuhan bakteri Methicillin-Resistant Staphylococcus aureus (MRSA) secara in vitro. Metode yang digunakan adalah metode difusi agar. Rerata diameter zona hambat kontrol negatif dengan etil asetat (K1)= 0 mm, konsentrasi 10% (P1) = 0 mm, 20% (P2) = 0 mm, 40% (P3)= 7,25 mm, dan 60% (P4) = 7,75 mm. Secara statistik ekstrak etil asetat daun kampoja (Plumeria rubra var. acutifolia) konsentrasi 40% dan 60% mampu menghambat pertumbuhan bakteri MRSA jika dibandingkan dengan kontrol negatif. Perlunya dilakukan penelitian lebih lanjut untuk fraksinasi ekstrak sehingga dapat diketahui senyawa manakah yang paling berperan sebagai antibakteri.
Kata Kunci: MRSA, daun kamboja, fitokimia
ABSTRACT
Imprudent use of antibiotics can lead to bacterial resistance to antibiotics. One of the bacteria that have showed resistance to antibiotic is Methicillin-Resistant Staphylococcus aureus (MRSA). Flavonoid and alkaloid were reported on frangipani leaves (Plumeria rubra var. acutifolia) contribute as an anti-bacterial agent. This finding leads an research to know deeper related to the efficacy of these compounds. This research aimed to know the anti-bacterial effect of etyl acetate extract of Plumeria rubra var. acutifolia leaves on MRSA. The method used is agar diffusion method . The average of inhibition zones of negative control with ethyl acetate (K1) = 0 mm, concentration 10% (P1) = 0 mm, 20% (P2) = 0 mm, 40% (P3) = 7.25 mm, and 60% (P4) = 7.75 mm. This study showed that etyl asetate extract of frangipani leaves (Plumeria rubra var. acutifolia) at concentration of 40% and 60% could inhibit the growth of MRSA bacteria. It is necessary to do fractination to the extract to know which secondary metabolite that have the most potential antibacterial activity.
Keywords: MRSA, Frangipani leaves, phytochemical
PENDAHULUAN
Bakteri Methicillin-Resistant Staphylococcus aureus (MRSA) merupakan salah satu penyebab tersering infeksi nosokomial baik di negara maju maupun berkembang.1,2 Sampai saat ini antibiotik golongan glikopeptida seperti vankomisin dan teikoplanin masih menjadi pilihan terapi untuk infeksi sistemik oleh bakteri ini.3 Setelah ditemukannya kasus MRSA yang menunjukkan resistensi terhadap vankomisin atau disebut Vancomycin IntermediateResistant Staphylococcus aureus (VISA), membuat pengobatan infeksi MRSA menjadi semakin sulit.4
Oleh karena itu perlu dikembangkan alternatif terapi zat antibakteri baru yang dapat digunakan untuk pengobatan infeksi MRSA dan tentunya memiliki efek samping yang lebih minimal. Salah satu caranya adalah dengan pemanfaatan keanekaragaman hayati Indonesia berupa tanaman herbal yang memiliki kandungan fitokimia yang dapat berperan sebagai antibakteri. Kandungan fitokimia pada tanaman yang dapat memberikan aktivitas antibakteri adalah fenolik.5,6
Kandungan fenolik (seperti flavonoid dan tannin) ini ternyata juga terdapat pada tanaman kamboja (Plumeria rubra)7. Beberapa penelitian telah menguji efektivitas ekstrak daun kamboja untuk menghambat pertumbuhan berbagai jenis bakteri, salah satunya adalah Staphylococcus aureus (S. aureus) dan menunjukkan zona hambatan yang signifikan.7,8 Namun belum ada data ilmiah terkait penelitian ekstrak daun kamboja pada bakteri MRSA. Sehingga penelitian uji daya hambat ekstrak daun kamboja (Plumeria rubra var. acutifolia) untuk menghambat pertumbuhan bakteri MRSA secara in vitro perlu untuk dilakukan yang nantinya dapat dijadikan sebagai dasar penelitian secara in vivo selanjutnya.
BAHAN DAN METODE
Penelitian ini dilakukan di Laboratorium Mikrobiologi Fakultas Kedokteran Universitas Udayana (FK UNUD) pada bulan Juli hingga Desember tahun 2016. Penelitian telah mendapatkan kelayakan etik dari Komisi Etik Penelitian Fakultas Kedokteran Universitas Udayana/ Rumah Sakit Umum Pusat Sanglah dengan nomor 575/UN.14.2/Litbang/2016 tertanggal 29 Maret 2016. Rancangan penelitian yang digunakan adalah True Experimental Post Test Only Group Design untuk mengetahui pengaruh ekstrak etil asetat daun kamboja (P.rubra var. acutifolia) dalam menghambat pertumbuhan MRSA secara in vitro. Pengujian dilakukan denga metode difusi agar (Kirby-Bauer) dengan menggunakan empat jenis konsentrasi ekstrak yaitu 10% (P1), 20% (P2), 40% (P3), dan 60% (P4),
serta menggunakan pembanding kontrol negatif etil asetat (K1) dan kontrol positif linezolid (K2).
Daun kamboja spesies P.rubra var. acutifolia dipetik dari tanaman yang tumbuh di daerah Waturenggong, Denpasar, Bali dengan memilih daun yang berwarna hijau, sudah dewasa, dan tidak terserang hama penyakit. Pembuatan ekstrak dilakukan di Laboratorium Sumberdaya Genetika dan Biologi Molekuler Universitas Udayana dengan memakai teknik maserasi dengan menggunakan pelarut etil asetat. Daun kamboja yang sudah dibersihkan dengan air bersih kemudian dipotong-potong kecil menggunakan pisau, kemudian dikeringkan tanpa sinar matahari atau dengan menggunakan oven dengan suhu 400C. Setelah kering, daun kamboja dihaluskan dengan blender. Sesudah itu, hasil ayakan ditimbang sebanyak 250 g kemudian dimasukkan ke dalam gelas erlemeyer kemudian direndam dengan etil asetat 650 ml. Campuran larutan tersebut diaduk selama 15-30 menit dan didiamkan selama 2 malam sampai mengendap. Setelah itu filtrat (lapisan atas yang berupa campuran etil asetat dengan zat aktif) diambil dan residu dimaserasi kembali dengan 500 ml etil asetat selama semalam. Selanjutnya filtrat diambil lagi dan residu dimaserasi kembali sampai empat kali pengulangan.
Setelah semua filtrat ekstrak daun kamboja diperoleh lalu difiltrasi menggunakan kertas Whatmann 0,1 dan dievaporasi dengan rotary evaporator pada suhu 400 C sehinga diperoleh ekstrak kering. Ekstrak etil asetat daun kamboja 100% diencerkan dengan etil asetat bila akan digunakan untuk membuat larutan dengan kosentrasi ekstrak 10%, 20%, 40%, dan 60%.
Media yang digunakan untuk menumbuhkan bakteri MRSA adalah media agar Mueller-Hinton (MH). Bakteri MRSA yang dipakai adalah MRSA ATCC 3351 yang didapat dari Laboratorium Mikrobiologi FK UNUD yang direjuvenasi terlebih dahulu sebelum digunakan. Biakan bakteri yang berumur 24 jam disuspensi sehingga kekeruhannya setara 0,5 Mc Farland dengan konsentrasi bakteri 1 x 108 CFU/ml. Suspensi bakteri kemudian dioleskan ke media agar kemudian diletakkan 6 disk yang masing-masing berisi kontrol negatif, kontrol positif, dan empat macam konsentrasi ekstrak. Jumlah pengulangan yang dilakukan dalam penelitian ini adalah sebanyak 4 kali sesuai perhitungan rumus Federer.
Lempeng agar yang sudah berisi bakteri mrsa, bahan uji, dan kontrol diinkubasi selama
18-24 jam pada suhu 35-370C. Data yang diambil dan dikumpulkan, berupa data kuantitatif diameter zona hambat ekstrak daun kamboja yang diukur menggunakan jangka sorong, kemudian dilakukan analisis data.
HASIL
Pengukuran diameter zona hambat dilakukan dengan jangka sorong pada zona bening di sekitar disk bahan uji dan kontrol. Pengukuran dilakukan dari beberapa sisi lingkaran disk. Hasil yang didapatkan dari empat kali pengulangan kemudian dihitung reratanya sehingga diperoleh rerata K1 = 0 mm, K2 = 32,50 P1 = 0,00 mm, P2 = 0,00 mm, P3 = 7,25 mm, dan P4 = 7,75 mm.
Gambar 1. Hasil Uji Ekstrak Etil Asetat Daun Kamboja (Plumeria rubra var. acutifolia) konsentrasi 10%, 20%, 40%, dan 60%, dibandingkan dengan kontrol negatif (larutam etil asetat) dan kontrol positif (antibiotik linezolid) pada Bakteri MRSA. Daya hambat ditunjukkan sebagai zona bening disekitar ekstrak atau antibiotik
Tabel 1. Data Hasil Pengukuran Diameter Zona Hambat Ekstrak Etil Asetat Daun Kamboja pada Bakteri MRSA
|
No |
K1 (mm) |
K2 (mm) |
P1 (mm) |
P2 (mm) |
P3 (mm) |
P4 (mm) |
|
1 |
0,00 |
33,00 |
0,00 |
0,00 |
7,00 |
7,00 |
|
2 |
0,00 |
32,00 |
0,00 |
0,00 |
7,00 |
8,00 |
|
3 |
0,00 |
33,00 |
0,00 |
0,00 |
7,00 |
7,00 |
|
4 |
0,00 |
32,00 |
0,00 |
0,00 |
8,00 |
9,00 |
Uji fitokimia dilakukan untuk mengetahui jenis senyawa metabolit sekunder yang terdapat didalam ekstrak etil asetat daun kamboja (Plumeria rubra var. acutifolia). Penulis melakukan uji terhadap beberapa senyawa seperti alkaloid, saponin, flavonoid, steroid, triterpenoid, fenol, dan glikosida di Laboratorium Fitokimia Farmasi Udayana.
Tabel 2. Hasil Uji Fitokimia Ekstrak Etil Asetat Daun Kamboja ((Plumeria rubra var. acutifolia)
|
Identifikasi Golongan Senyawa |
Metode Pengujian |
Pengamatan |
Hasil |
|
Alkaloid |
Meyer |
Terbentuk endapan putih |
+ |
|
Bouchardat |
Terbentuk endapan hitam |
+ | |
|
Wagner |
Terbentuk endapan coklat |
+ | |
|
Saponin |
Foam |
Terbentuk busa yang stabil |
+ |
|
Flavonoid |
Pew |
Terbentuk warna kuning intensif |
+ |
|
Steroid |
Lieberman-Burchard |
Terbentuk cincin warna biru kehijauan |
+ |
|
Triterpenoid |
Lieberman-Burchard |
Terbentuk cincin kecoklatan |
+ |
|
Fenol |
FeCl3 2% |
Terbentuk warna biru kehitaman |
+ |
|
Glikosida |
Lieberman-Burchard |
Terbentuk warna Hijau kebiruan |
+ |
PEMBAHASAN
Hasil penelitian menunjukkan terjadinya efek menghambat ekstrak terhadap bakteri MRSA pada konsentrasi 40% dan 60%. Efek menghambat terjadi karena ekstrak etil asetat daun kamboja mengandung
beberapa zat anti bakteri aktif seperti triterpenoid, flavonoid, alkaloid, saponin dan fenol yang menunjukkan hasil yang positif dari hasil uji fitokimia.
Cara kerja dari masing-masing senyawa tersebut sebagai agen antibakteri sebenarnya masih belum jelas namun pada beberapa penelitian meyebutkan adalah dengan mempengaruhi dinding sel bakteri baik dengan cara meningkatkan atau merusak permebilitas membran maupun dengan mengganggu sintetis salah satu komponen dinding sel bakteri yaitu peptidoglikan. Peningkatan permeabilitas pada membran dan dinding sel bakteri akan memicu terjadinya kebocoran sehingga menyebabkan komponen intraseluler akan keluar atau terjadinya lisis pada sel bakteri. Metabolit sekunder yang dilaporkan berperan dalam mekanisme tersebut adalah flavonoid dan saponin. Sementara senyawa yang dilaporkan memiliki aktivitas antibakteri dengan mengganggu sintesis komponen peptidoglikan adalah alkaloid.9 Sementara data terkait aktivitas senyawa lainnya sebagai antibakteri belum dilaporkan.
Keefektifan penyerapan senyawa antibakteri dan senyawa aktif lainnya yang terkadung dalam daun kamboja juga tidak terlepas dari pelarut yang digunakan dalam proses ekstraksi. Penelitian mengenai ekstrak daun kamboja (Plumeria rubra) sebelumnya pernah dilakukan oleh Lawal U dkk7 pada tahun 2014 di Kaduna, Nigeria. Pada penelitian tersebut dilakukan perbandingan potensi ekstrak daun kamboja sebagai antibakteri dengan menggunakan beberapa jenis pelarut yang berbeda seperti etil asetat, heksana, dan metanol untuk proses ekstraksi. Ekstrak yang dibuat dengan pelarut etil asetat menunjukkan kemampuan menghambat bakteri Staphylococcus aureus (S. aureus) NCIB8588 yang paling besar yaitu 21 mm pada konsentrasi 20 mg/ml. Hal yang sama juga ditunjukkan oleh penelitian Baghel dkk10 yang membandingkan efektifitas ekstrak etanol, klorofom, etil asetat, dan air daun kamboja (Plumeria rubra. Linn) dalam menghambat bakteri S. epidermidis dan E. coli. Ekstrak yang paling efektif dalam menghambat kedua jenis bakteri tersebut adalah ekstrak yang dibuat dengan pelarut etil asetat.
Perbandingan keefektifan ekstrak etil asetat dan etanol daun kamboja (Plumeria rubra var. acutifolia) juga dapat ditunjukkan dari hasil pengujian penulis sebelumnya. Pada pengujian ekstrak etanol daun kamboja terhadap pakteri S.aureus dan MRSA diperoleh hasil yang negatif pada semua konsentrasi yang dicoba (20%, 30%, 40%, dan 50%). Sementara, pada penelitian penulis yang menggunakan ekstrak etil asetat daun kamboja menunjukkan daya hambat sebesar 7 mm pada konsentrasi 40% dan 7-8 mm pada konsentrasi 60% bakteri Staphylococcus aureus (data tidak ditampilkan).
Kandungan dan jumlah senyawa aktif dapat dipengaruihi oleh lokasi pengambilan sampel daun. Hal ini terjadi karena kadar dan jenis metabolit sekunder dari ekstrak dalam suatu tanaman akan sangat dipengaruhi oleh faktor biotik dan abiotik lingkungan hidupnya. Fungsi ekologis dari metabolit sekunder tanaman salah satunya adalah untuk melindungi diri dari mamalia herbivora dan mikroorganisme penyebab infeksi. Senyawa metabolit sekunder ini akan sangat mempengaruhi kemampuan dari suatu tanaman untuk beradaptasi di suatu lingkungan.11 Dengan kata lain semakin mengancamnya kondisi suatu lingkungan hidup maka tanaman akan memproduksi senyawa metabolit sekunder yang lebih banyak untuk pertahanan diri. Selain itu beberapa faktor abiotik seperti suhu, intensitas radiasi cahaya, air, ketinggian, paparan sinar UV, dan komposisi udara juga mempengaruhi produksi senyawa metabolit sekunder. Seperti sintesis derivat fenolik dan alkaloid akan banyak terbentuk pada paparan cahaya yang tinggi. Flavonoid akan melindungi tanaman dari paparan sinar UV, sehingga pada kondisi dimana paparan sinar UV tinggi, maka tanaman akan memproduksi flavonoid yang lebih banyak. Begitupula pada kondisi stres air akan memicu biosintesis alkaloid purin.12
Hasil uji fitokimia ekstrak etil asetat daun kamboja yang penulis lakukan menunjukkan hasil yang positif pada tujuh jenis senyawa metabolit sekunder yang diuji yaitu alkaloid, saponin, steroid, flavonoid, triterpenoid, fenol, dan glikosida. Sementara pada penelitian Lawal U dkk hasil uji fitokimia ekstrak etil asetat daun kamboja menunjukkan hasil positif terhadap senyawa tannin, saponin, steroid, dan glikosida. Hasil yang berbeda ini salah satunya dapat dipengaruhi oleh lokasi pengambilan daun.7
Penelitian ini menunjukkan bahwa ekstrak etil asetat daun kamboja (Plumeria rubra var acutifolia) memiliki potensi sebagai anti bakteri terhadap bakteri MRSA. Namun, perlu untuk dilakukan penelitian lanjutan untuk mengetahui senyawa metabolit sekunder yang paling berperan sebagai antibakteri dengan melakukan fraksinasi kandungan ekstrak. Pembaharuan atau inovasi metode ekstraksi daun kamboja juga diperlukan sebagai salah satu pendekatan untuk mendapatkan konsentrasi senyawa antibakteri yang terkandung didalamya.
SIMPULAN DAN SARAN
Simpulan
Adapun simpulan dari penelitian ini adalah ekstrak etil asetat daun kamboja (Plumeria rubra var. acutifolia) konsentrasi 40% dan 60% dapat
menghambat pertumbuhan bakteri MRSA secara in 5.
vitro.
Saran
Beberapa saran yang dapat diberikan melalui penelitian ini antara lain:
6.
-
a. Penelitian lebih lanjut untuk mengetahui senyawa metabolit sekunder yang paling berperan sebagai antibakteri dengan melakukan fraksinasi kandungan ekstrak, kemudian diuji cobakan lagi pada bakteri MRSA secara in vitro. 7.
-
b. Pembaharuan atau inovasi metode ekstraksi daun kamboja juga diperlukan sebagai salah satu pendekatan untuk mendapatkan konsentrasi senyawa antibakteri yang terkandung didalamya.
8.
DAFTAR PUSTAKA
-
1. Kock, R., Mellmann, A., Schaumburg, F., W.
Friedrich, A., Kipp, F. and Becker, K. The Epidemiology of Methicillin-Resistant 9.
Staphylococcus aureus (MRSA) in Germany.
Deutsches Ärzteblatt International.
2011;108(45):763.
-
2. Huang H, Flynn N, King J, Monchaud C, Morita
M, Cohen S. Comparisons of Community- 10
Associated Methicillin-Resistant
Staphylococcus aureus (MRSA) and Hospital-Associated MSRA Infections in Sacramento, California. Journal of Clinical Microbiology. 11
2006; 44(7): 2423-2427.
-
3. WHO.Antimicrobial Resistance Global Report on Surveillance. WHO Library Cataloguing in Publication Data. 2014:20
-
4. Kurosu M, Siricilla S, Mitachi K. Advances in
MRSA drug discovery: where are we and where 12
do we need to be?. Expert Opinion on Drug Discovery. 2013; 8(9): 1095-1116.
Nohynek L, Alakomi H, Kähkönen M, Heinonen M, Helander I, Oksman-Caldentey K dkk. Berry Phenolics: Antimicrobial Properties and
Mechanisms of Action Against Severe Human Pathogens. Nutrition and Cancer. 2006;54(1): 18-32.
Huang W, Zhang H, Liu W, Li C. Survey of antioxidant capacity and phenolic composition of blueberry, blackberry, and strawberry in Nanjing. J Zhejiang Univ Sci B.13(2). 2012: 94102.
Lawal U., Egwaikhide P. A., and Longbap D.B. Preliminary Phytochemical and Anti-Bacterial Studies on the Leaf Extracts of Plumeria Rubra Linn. Journal of Natural Sciences Research. 2014; 4(14): 74-76.
Kumar, N and Kr. Sharma, S. Antimicrobial potential of Plumeria rubra Syn Plumeria acutifolia bark. Scholars Research Library. 2012; 4(4):1592.
Lusi, D. and Widya, L. Uji Aktivitas Antibakteri Ekstrak Daun Kelor (Moringa Oleifera L.) Terhadap Bakteri Escherichia coli dan Staphylococcus aureus. Pharmacon Jurnal Ilmiah Farmasi-UNSRAT. 2016; 5(2): 288.
Baghel S. A., Mishra K. C., Rani, A., Sasmal, D., Nema K. R. Antibacterial activity of Plumeria rubra Linn. plant extract. Journal of Chemical and Pharmaceutical Researc 2010; 2(6): 435-44. Vince, Ö. and Zoltán, M. (2011). Plant
Physiology|Digital Textbook Library. [online] Tankonyvtar.hu. Diunduh dari:
http://www.tankonyvtar.hu/en/tartalom/tamop42 5/0010_1A_Book_angol_01_novenyelettan/ch0 3s05.html [Diakses 6 Nov. 2016].
Pavarini, D., Pavarini, S., Niehues, M. and Lopes, N. Exogenous influences on plant secondary metabolite levels. Animal Feed Science and Technology 2012;176(1-4): 5-16.
https://ojs.unud.ac.id/index.php/eum
doi:10.24843.MU.2020.V9.i4.P09
57
Discussion and feedback